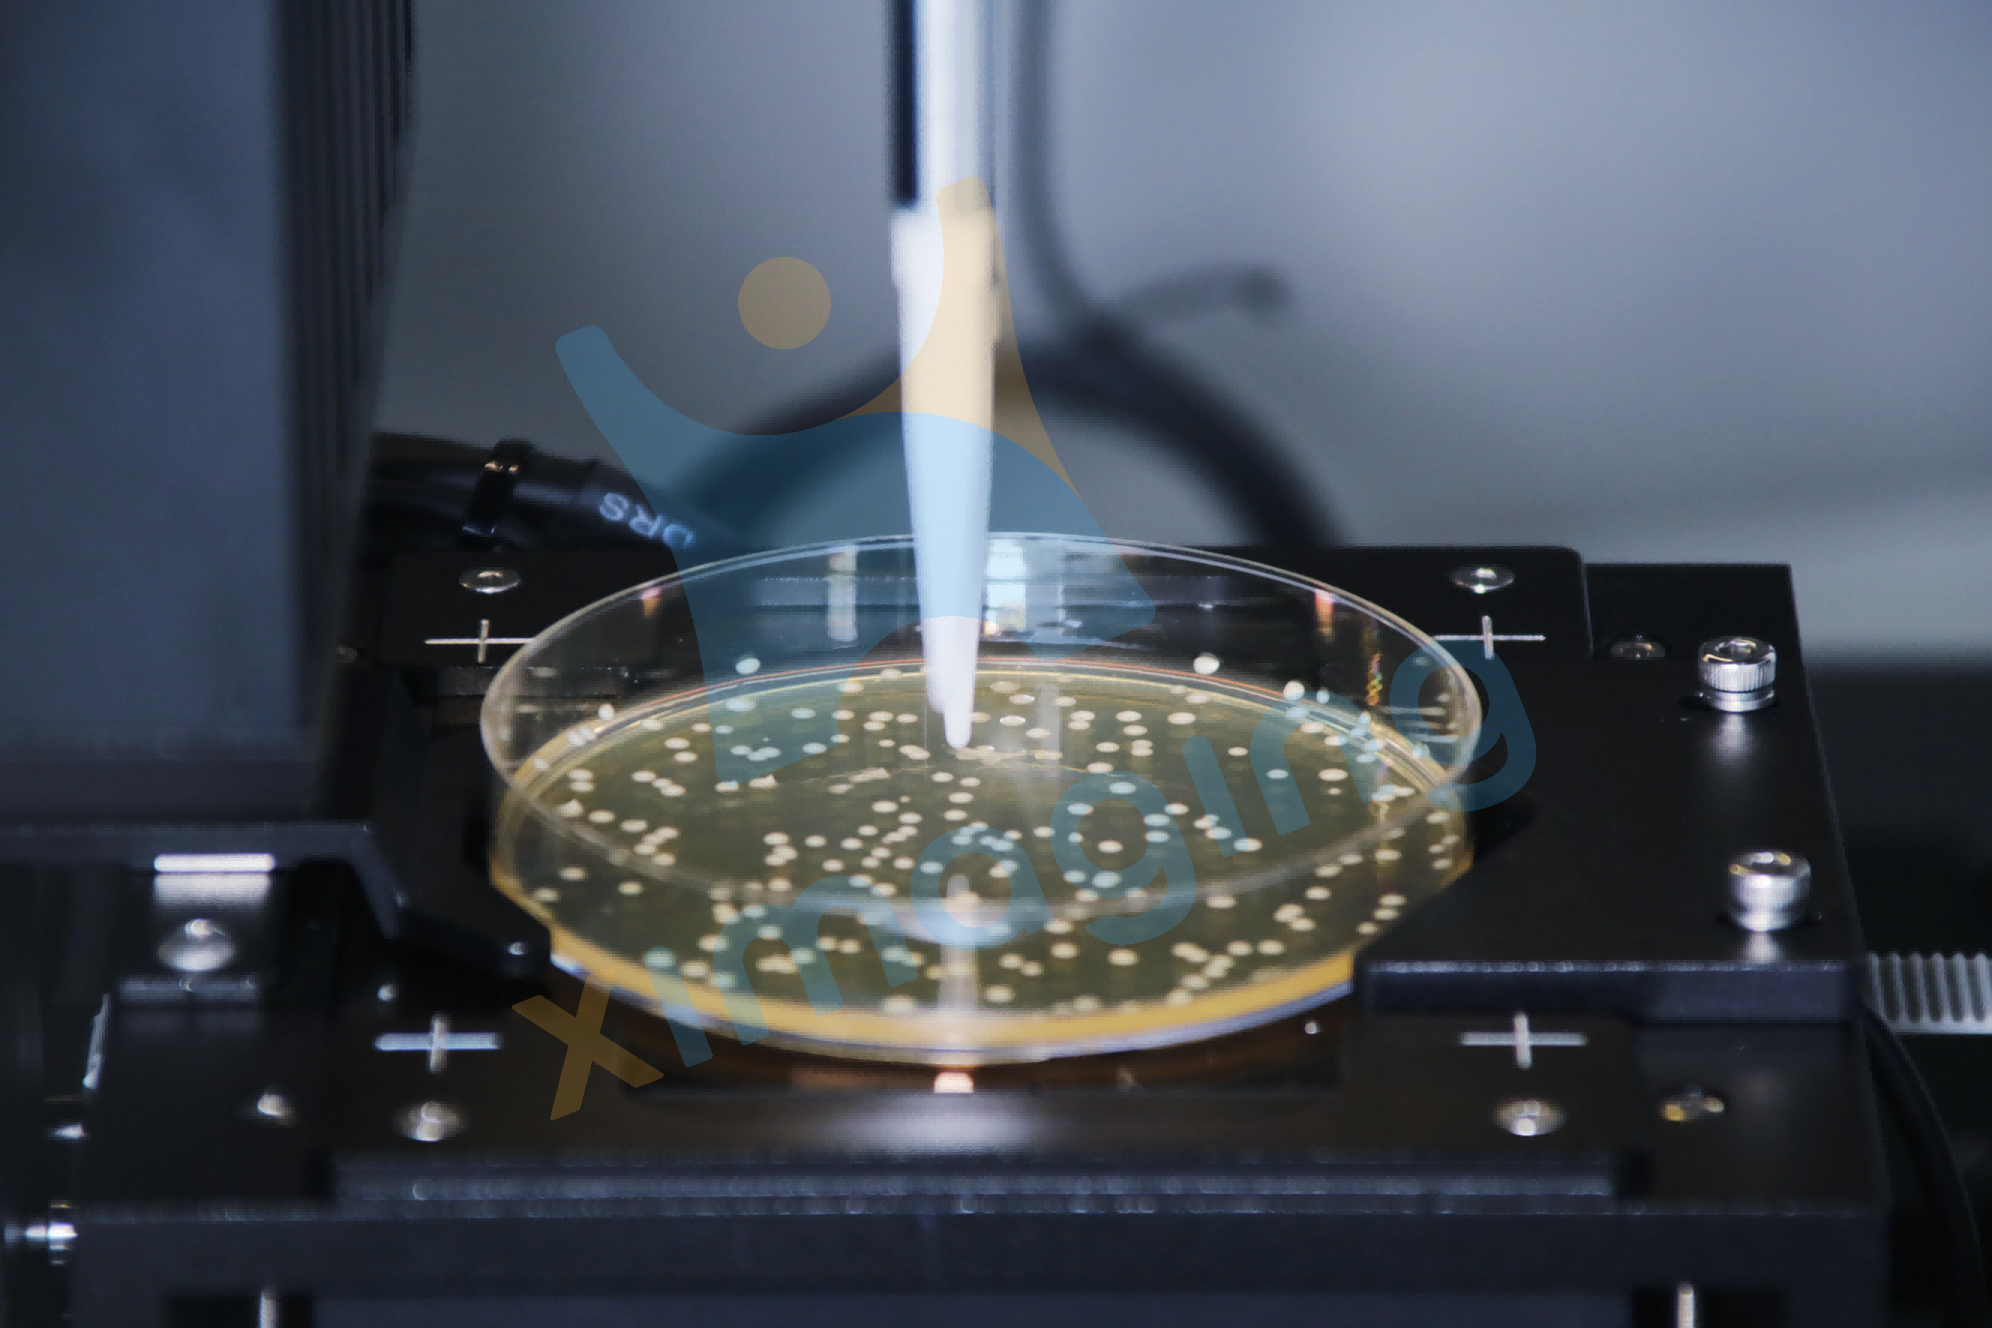

新聞資訊
更新時(shí)間:2025-11-24
點(diǎn)擊次數(shù):57
從1911年Stephane Leduc《The Mechanism of Life》中“形狀和結(jié)構(gòu)的合成"的歸納,到21世紀(jì)初,系統(tǒng)代謝工程技術(shù)的發(fā)展、工程化理念的深入和工程工具的積淀,合成生物學(xué)持續(xù)高速發(fā)展。合成生物學(xué)的目的在于建立人工生物系統(tǒng),讓它們像電路一樣運(yùn)行,其核心策略是通過(guò)“設(shè)計(jì)(Design)—構(gòu)建(Build)—測(cè)試(Test)—學(xué)習(xí)(Learn)"(DBTL)的循環(huán)對(duì)遺傳部分或生物體連續(xù)通過(guò)迭代過(guò)程進(jìn)行改進(jìn)。

盡管發(fā)展迅速,合成生物學(xué)應(yīng)用仍受限于產(chǎn)品規(guī)?;a(chǎn)、研發(fā)成本控制、人力完成耗時(shí)過(guò)久等挑戰(zhàn)。人工智能與自動(dòng)化技術(shù)的結(jié)合,成為合成生物學(xué)研究突破瓶頸的有利工具,通過(guò)自動(dòng)化系統(tǒng)實(shí)現(xiàn)對(duì)生物體的精確控制和大規(guī)模操作,通過(guò)機(jī)器學(xué)習(xí)算法訓(xùn)練大量的數(shù)據(jù),正在加速合成生物學(xué)研究的進(jìn)程。

作為一家專注科學(xué)領(lǐng)域的人工智能技術(shù)企業(yè),匯像科技(XImaging)以機(jī)器人、AI為核心,為合成生物學(xué)領(lǐng)域提供全系統(tǒng)的智慧自動(dòng)化解決方案。匯像自主研發(fā)的iMagicOS智慧魔法操作系統(tǒng),融合人工智能(AI) 、生物技術(shù)、數(shù)據(jù)分析、機(jī)器學(xué)習(xí)(ML) 和建模等多學(xué)科技術(shù),為打造合成生物學(xué)智慧實(shí)驗(yàn)室新生態(tài)而生。
自動(dòng)化助力"DBTL"增效提質(zhì)
—— 全自動(dòng)·高通量——
匯像科技提供合成生物學(xué)從微生物培養(yǎng)、改造、篩選、鑒定、發(fā)酵生產(chǎn)等多環(huán)節(jié)的自動(dòng)化智能化解決方案,實(shí)現(xiàn)全流程實(shí)驗(yàn)自動(dòng)化的同時(shí),對(duì)過(guò)程數(shù)據(jù)、環(huán)境數(shù)據(jù)進(jìn)行提取和解析,追溯樣品全生命周期??蓮V泛應(yīng)用于農(nóng)業(yè)微生物改造、農(nóng)業(yè)分子育種、工業(yè)化底盤細(xì)胞改造篩選、環(huán)境微生物細(xì)胞定向改造、醫(yī)學(xué)健康等領(lǐng)域,助力生物智造DBTL循環(huán)增效提質(zhì)。
HostaH 多功能液體工作站
— 讓復(fù)雜實(shí)驗(yàn)流程變得簡(jiǎn)單
Hosta H12移液工作站是專為實(shí)驗(yàn)室打造的緊湊型自動(dòng)化液體處理系統(tǒng),采用精巧結(jié)構(gòu)設(shè)計(jì),可快速部署于任何空間的實(shí)驗(yàn)室環(huán)境。工作站搭載4個(gè)1mL移液通道,可以靈活處理單樣本及多樣本。創(chuàng)新的轉(zhuǎn)板抓手設(shè)計(jì)可智能適配孔板、板蓋、EP管載架等多種實(shí)驗(yàn)耗材,實(shí)現(xiàn)精準(zhǔn)無(wú)誤的自動(dòng)化轉(zhuǎn)移。模塊化平臺(tái)設(shè)計(jì),用戶可根據(jù)實(shí)驗(yàn)需求自由配置各類耗材載架及功能模塊,輕松實(shí)現(xiàn)復(fù)雜工作流程的自動(dòng)化升級(jí)。配合內(nèi)置高精度視覺(jué)監(jiān)控系統(tǒng),全程追蹤液體處理過(guò)程,確保每個(gè)實(shí)驗(yàn)步驟都精準(zhǔn)可溯。


“海黛蘭"HedylaX智能微生物菌落挑選工作站
— 高性價(jià)比,解放人力,過(guò)程溯源
匯像科技“海黛蘭(HedylaX)"智能微生物菌落挑選工作站,將匯像專業(yè)的AI視覺(jué)識(shí)別技術(shù),液體處理技術(shù)和自動(dòng)化控制技術(shù)融為一體,通過(guò)自動(dòng)成像、智能識(shí)別和自動(dòng)操作控制,實(shí)現(xiàn)菌落挑選和接種的全過(guò)程自動(dòng)化,接種方式多樣,包括固-液接種,固-固接種、液-固接種和液-液接種。系統(tǒng)性價(jià)比高且支持通量擴(kuò)展,旨在解決人工挑菌效率低、不穩(wěn)定和無(wú)溯源等問(wèn)題。

基因合成系統(tǒng)
— 高效、精準(zhǔn)、安全、智能
該系統(tǒng)集成片段合成、氨解、純化、組裝及重組等核心步驟,通過(guò)模塊化設(shè)備和智能控制系統(tǒng)實(shí)現(xiàn)基因合成的全流程自動(dòng)化。依托AGV機(jī)器人實(shí)現(xiàn)各設(shè)備間的無(wú)人化轉(zhuǎn)運(yùn)對(duì)接,人員無(wú)需進(jìn)入操作區(qū)域,既從根本上規(guī)避了化學(xué)試劑對(duì)操作人員的潛在風(fēng)險(xiǎn),又通過(guò)消除人為接觸環(huán)節(jié)杜絕了樣本交叉污染,顯著提升實(shí)驗(yàn)結(jié)果的可靠性與重復(fù)性。系統(tǒng)以“高效、精準(zhǔn)、安全、智能"的核心優(yōu)勢(shì),為基因工程研究與應(yīng)用提供強(qiáng)力技術(shù)支撐。

原生質(zhì)體制備篩選自動(dòng)化系統(tǒng)
— 解放雙手,提速研究!精準(zhǔn)制備,智能篩選
原生質(zhì)體制備篩選自動(dòng)化系統(tǒng),通過(guò)標(biāo)準(zhǔn)化程序?qū)崿F(xiàn)原生質(zhì)體酶解、原生質(zhì)體計(jì)數(shù)、原生質(zhì)體培養(yǎng)、原生質(zhì)體轉(zhuǎn)化(電轉(zhuǎn)和PEG兼容)、原生質(zhì)體篩選(流式和化學(xué)發(fā)光檢測(cè)兼容)等原生質(zhì)體實(shí)驗(yàn)流程的關(guān)鍵步驟。
精準(zhǔn)控制,顯著提高制備效率和重復(fù)性,可實(shí)現(xiàn)高通量、標(biāo)準(zhǔn)化的原生質(zhì)體制備和篩選,為CRISPR基因編輯、啟動(dòng)子活性分析、蛋白互作研究等前沿課題提供關(guān)鍵技術(shù)支撐。

高通量改造篩選智慧自動(dòng)化實(shí)驗(yàn)室
高通量微生物改造篩選智慧實(shí)驗(yàn)室是一種集成自動(dòng)化實(shí)驗(yàn)系統(tǒng)、人工智能(AI)優(yōu)化和大數(shù)據(jù)分析的先進(jìn)研究平臺(tái),專注于對(duì)微生物(如細(xì)菌、酵母、真菌等)進(jìn)行大規(guī)模基因改造和高效表型篩選,以加速合成生物學(xué)、生物制造、醫(yī)藥研發(fā)等領(lǐng)域的突破。

智能植物基因元件篩選自動(dòng)化實(shí)驗(yàn)室
智能植物基因元件篩選自動(dòng)化實(shí)驗(yàn)室包含五個(gè)主要功能模塊:原生質(zhì)體制備篩選、基因合成、測(cè)序文庫(kù)構(gòu)建、自動(dòng)化質(zhì)粒構(gòu)建和高通量基因分型檢測(cè)平臺(tái)。流程包括植物組織測(cè)序文庫(kù)構(gòu)建、DNA片段合成、混合質(zhì)粒文庫(kù)構(gòu)建、原生質(zhì)體轉(zhuǎn)化、陽(yáng)性原生質(zhì)體流式分選和測(cè)序文庫(kù)構(gòu)建,以及一對(duì)一質(zhì)粒構(gòu)建和原生質(zhì)體轉(zhuǎn)化與篩選。
平臺(tái)配備數(shù)字孿生系統(tǒng),實(shí)時(shí)監(jiān)控和調(diào)整流程,提供詳細(xì)數(shù)據(jù)以供分析和優(yōu)化。部署數(shù)據(jù)庫(kù)和自動(dòng)化生物信息學(xué)數(shù)據(jù)處理平臺(tái),整合測(cè)序和分析軟件,實(shí)現(xiàn)全流程自動(dòng)化處理,加快研發(fā)周期,提高效率。

共創(chuàng)未來(lái)
21世紀(jì)是生物的世紀(jì),合成生物學(xué)、AI和自動(dòng)化的創(chuàng)新融合成為一個(gè)重要的機(jī)遇。匯像科技將持續(xù)深入布局,用自動(dòng)化為合成生物學(xué)的發(fā)展插上翅膀,以AI智慧大腦助力合成生物學(xué)實(shí)現(xiàn)從自動(dòng)化到數(shù)字化再到智慧化的跨越和升級(jí)。未來(lái)的某一天,物理世界到生物數(shù)字世界順利橋接,生物孿生數(shù)字合成智慧中心將真正實(shí)現(xiàn),這將是匯像科技在合成生物學(xué)領(lǐng)域努力實(shí)現(xiàn)的方向。
關(guān)于匯像科技
匯像科技(XImaging)是一家專注于科學(xué)研究與生命健康領(lǐng)域的人工智能技術(shù)公司,致力于為食品、制藥、環(huán)境、臨床診斷與分析檢測(cè)行業(yè)提供智能自動(dòng)化產(chǎn)品與系統(tǒng)解決方案。
匯像科技總部位于上海市,毗鄰上海交通大學(xué)與華東師范大學(xué),作為專精特新企業(yè)以及中國(guó)生物資源與生物設(shè)施聯(lián)盟單位,匯像科技一直本著“用AI成就科學(xué)之美"的創(chuàng)業(yè)初心,致力于成為客戶在AI時(shí)代下的最佳智能化合作伙伴。